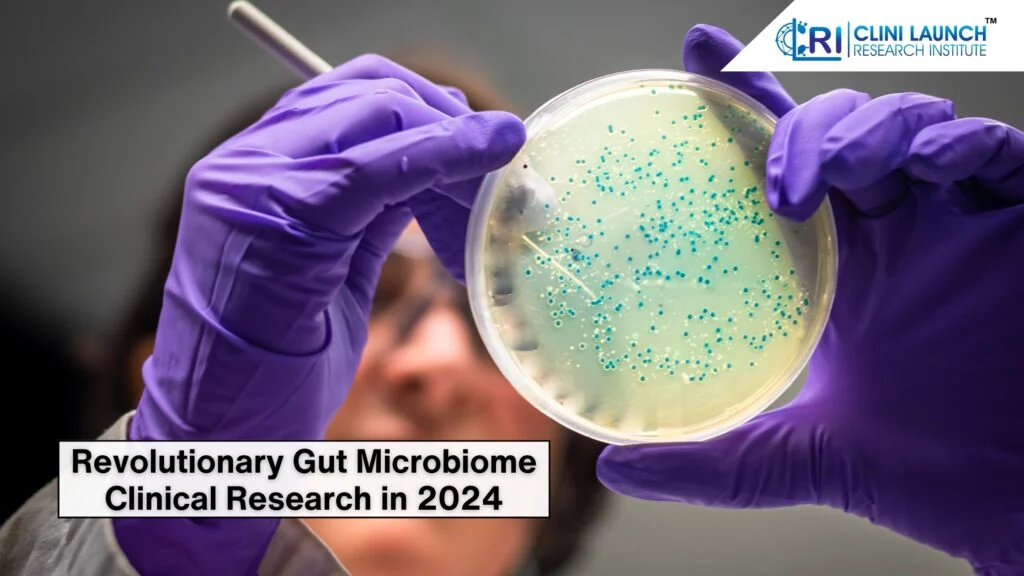
Revolutionary Gut Microbiome Clinical Research in 2024

Gut microbiome clinical research is unveiling the underlying workings of our environment, demonstrating how billions of microbes affect our health and sickness.
The human body is a complex ecosystem teeming with billions of bacteria, known as the microbiome. This complicated community has a significant impact on human health. The gut microbiota which is a key component of the microbiome, lives in the gastrointestinal system and has a substantial impact on digestion, immunity, and general health. Understanding the role of gut bacteria in health is critical for addressing the impact of the microbiome on disease.
Recognizing the importance of these aspects, researchers have stepped up their attention on gut microbiome clinical research. This new discipline aims to better understand the complicated interaction between gut bacteria and human health to create novel disease prevention, diagnostic, and treatment options.
A thorough knowledge of the role of gut microbiota in health is critical for furthering clinical studies on gut bacteria and improving patient outcomes.
The Gut Microbiome – A Complex Ecosystem
The human gut has a huge and complex ecosystem made up of billions of bacteria known as the gut microbiome. This complex community, composed of bacteria, viruses, and fungi, plays a crucial role of gut microbiota in health. The composition and function of the gut microbiome are influenced by a multitude of factors, including diet, antibiotics, host genetics, and environmental exposures.
Diet, for example, is a substantial influence on gut microbiota makeup. Consumption of fibre-rich meals encourages the growth of beneficial bacteria, but excessive consumption of processed foods disrupts the microbial equilibrium. While antibiotics are necessary for infection control, they can unintentionally affect the gut microbiome, potentially causing health problems. Host genetics also help to shape the gut microbiome makeup, which influences susceptibility to specific illnesses. Environmental variables, such as pollution and chemical exposure, can also influence the gut’s microbial ecology.
Dysbiosis, or an imbalance in the gut microbiome, is linked to various health concerns. This alteration of the microbial environment can cause inflammation, decreased immunological function, and an increased risk of illness. Understanding the causes that cause dysbiosis is critical for finding effective therapies to restore microbial equilibrium.
The Gut Microbiome and Human Health – A Reciprocal Relationship

The link between the gut microbiota and human health is complicated and bidirectional. A healthy gut microbiota is necessary for proper digestion, food absorption, and immunological function. The gut-brain axis, a communication route between the gastrointestinal system and the brain, emphasizes the gut microbiome’s effect on mood, behavior, and cognitive performance.
Emerging evidence reveals that the gut microbiome is important in many areas of human health. It aids in the production of key vitamins, such as vitamin K and B vitamins, which are required for many body activities. Furthermore, the gut microbiome protects against infections by establishing a barrier and boosting the immune system.
The gut microbiome has also emerged as a possible biomarker for various medical diseases.
Specific microbial patterns have been related to illnesses including inflammatory bowel disease, irritable bowel syndrome, and even obesity. Understanding the role of gut microbiota in health allows researchers to create innovative diagnostic tools and treatment therapies.
The Gut Microbiome and Disease – A Mechanistic Understanding
A rising amount of data supports the gut microbiome’s role in the etiology of several chronic illnesses. Dysbiosis, or microbial imbalance, has been linked to inflammatory bowel disease, irritable bowel syndrome, type 2 diabetes, obesity, and even some neurological problems.
The methods by which the gut microbiome contributes to illness are complex and multifaceted. Inflammation has a significant role in many microbiome-related disorders. Dysbiosis can cause increased intestinal permeability, letting toxic chemicals into the circulation and triggering an inflammatory reaction. Furthermore, the gut microbiota might affect the immune system, contributing to autoimmune disorders.
Understanding the molecular relationship between the gut microbiome and illness is critical for establishing successful treatment solutions. Targeting the gut microbiome with therapies like probiotics, prebiotics, and faecal microbiota transplantation has the potential to prevent and treat a wide range of disorders.
Biostatistics and Bioinformatics Connection

To fully realize the potential of gut microbiome clinical research, a strong grasp of biostatistics or bioinformatics is required. Breaking down the understanding of each professional skill, biostatistics is critical for planning well-powered clinical trials, analyzing complicated data, and reaching relevant findings. Whereas bioinformatics is critical for managing, analyzing, and interpreting large volumes of microbiome data.
CliniLaunch provides extensive materials and courses in biostatistics and bioinformatics for candidates interested in upskilling their careers in healthcare.
Visit CliniLaunch to learn how these disciplines might benefit your microbiome research.
Gut Microbiome Clinical Research – Advancing the Field
Gut microbiome clinical research is tremendously evolving to unravel the intricate relationship between the gut microbiota and human health. A variety of approaches, including observational studies, randomized controlled trials (RCTs), and meta-analyzes, are used to explore the impact of the microbiome on disease. While this research provides useful insights, obstacles such as data standardization, sophisticated analysis, and ethical issues remain. Interdisciplinary collaboration is required to overcome these challenges and expedite development.
The Future of Gut Microbiome Clinical Research – A Precision Medicine Approach

The direction of gut microbiome clinical research speaks to a future of personalized treatment. By studying individual gut microbiomes, researchers hope to find distinct microbial fingerprints linked to various health issues. The precision medicine approach has the potential to transform illness prevention, diagnosis, and therapy.
The development of microbiome-based therapeutics such as probiotics and facial microbiota transplantation is gaining traction. However, ongoing research and funding are required to turn these promising possibilities into practical therapeutic applications.
Conclusion
The gut microbiota has emerged as a key factor influencing human health and illness. Understanding the role of gut microbiota in health is critical for creating effective strategies to mitigate the impact of the microbiome on disease. Gut microbiome clinical research is at the forefront of converting these insights into real-world benefits for patients. Continued funding in clinical studies on gut bacteria is required to realize the microbiome’s full potential for better health outcomes.
Consider learning more about gut microbiome clinical research with CliniLaunch. Our extensive training programs provide researchers with the information and skills they need to succeed in this dynamic area. Visit CliniLaunch to explore our options and empower yourself to lead revolutionary research.

Krishna Talreja
Dynamic content marketing professional with expertise in brand storytelling and strategic content creation. Adept at managing diverse content projects, driving engagement, and enhancing brand visibility across multiple platforms.
